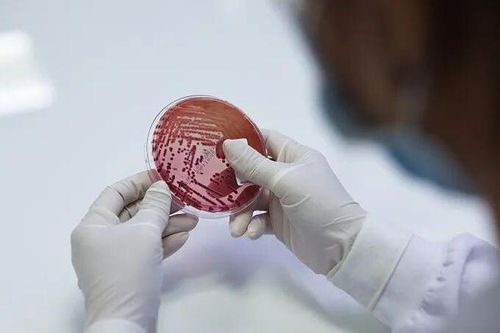
÷Щ֢״ ÷ܳ

患上梅毒有哪些症状 梅毒能彻底治愈吗
梅毒的临床表现及其影响深远
从潜伏梅毒到三期梅毒(晚期梅毒),梅毒的每一个分期都有其独特的临床表现和深远的影响。让我们一起揭开梅毒的神秘面纱,了解其不同阶段的特征。
潜伏梅毒:在这一阶段,患者已被医学确认为梅毒感染者,然而他们的皮肤和黏膜、各器官系统以及脑脊液检查均未显示出明显的异常。尽管外表看似正常,但患者的梅毒血清反应呈阳性,或者他们具有明确的梅毒感染历史却从未表现出任何症状。
一期梅毒:此期的平均潜伏期约为3-4周。典型的症状是硬下疳,通常出现在外阴部及性接触部位。这些部位可能出现包皮水肿,并在阴茎背部引发淋巴管炎。对于女性患者,硬下疳可能出现在大阴唇、阴蒂、尿道口和阴阜等地。如果不接受治疗,硬下疳可能在3-4周内自行愈合,但经过有效治疗后可以迅速恢复,留下浅表的萎缩性疤痕。
二期梅毒:这是梅毒的泛发期,此时梅毒螺旋体已扩散至全身。在硬下疳消失后的3-4周,即感染后的9-12周,会出现二期梅毒疹。此阶段,除了对皮肤造成损害,还可能侵犯内脏及神经系统。在此前,患者可能出现类似流感的征兆,如头痛、低热、四肢酸痛等。
三期梅毒(晚期梅毒):这一阶段通常出现在发病后的2年,但也可能更长时间,达到3-5年。此阶段主要影响40-50岁的人群,如果未经充分治疗或治疗不当,预后将会不良。晚期梅毒可能导致组织器官的破坏,使其功能丧失,甚至导致残疾或死亡。
关于梅毒能否治愈的问题,医学专家明确表示,只要及早发现并采取科学有效的治疗,梅毒是可以治愈的。梅毒的危害不容忽视。它可能引发多种症状,影响患者的正常生活。未治愈的情况下,梅毒还可能传染给伴侣或子女,危害他们的健康。对于梅毒患者来说,及早接受科学治疗是至关重要的。
面对梅毒,我们应该保持高度警惕,及时发现并治疗,避免其带来的危害。了解梅毒的临床分期及其特点,有助于我们更好地预防和治疗这一疾病。让我们共同努力,提高对梅毒的认识,保护自己和他人的健康。